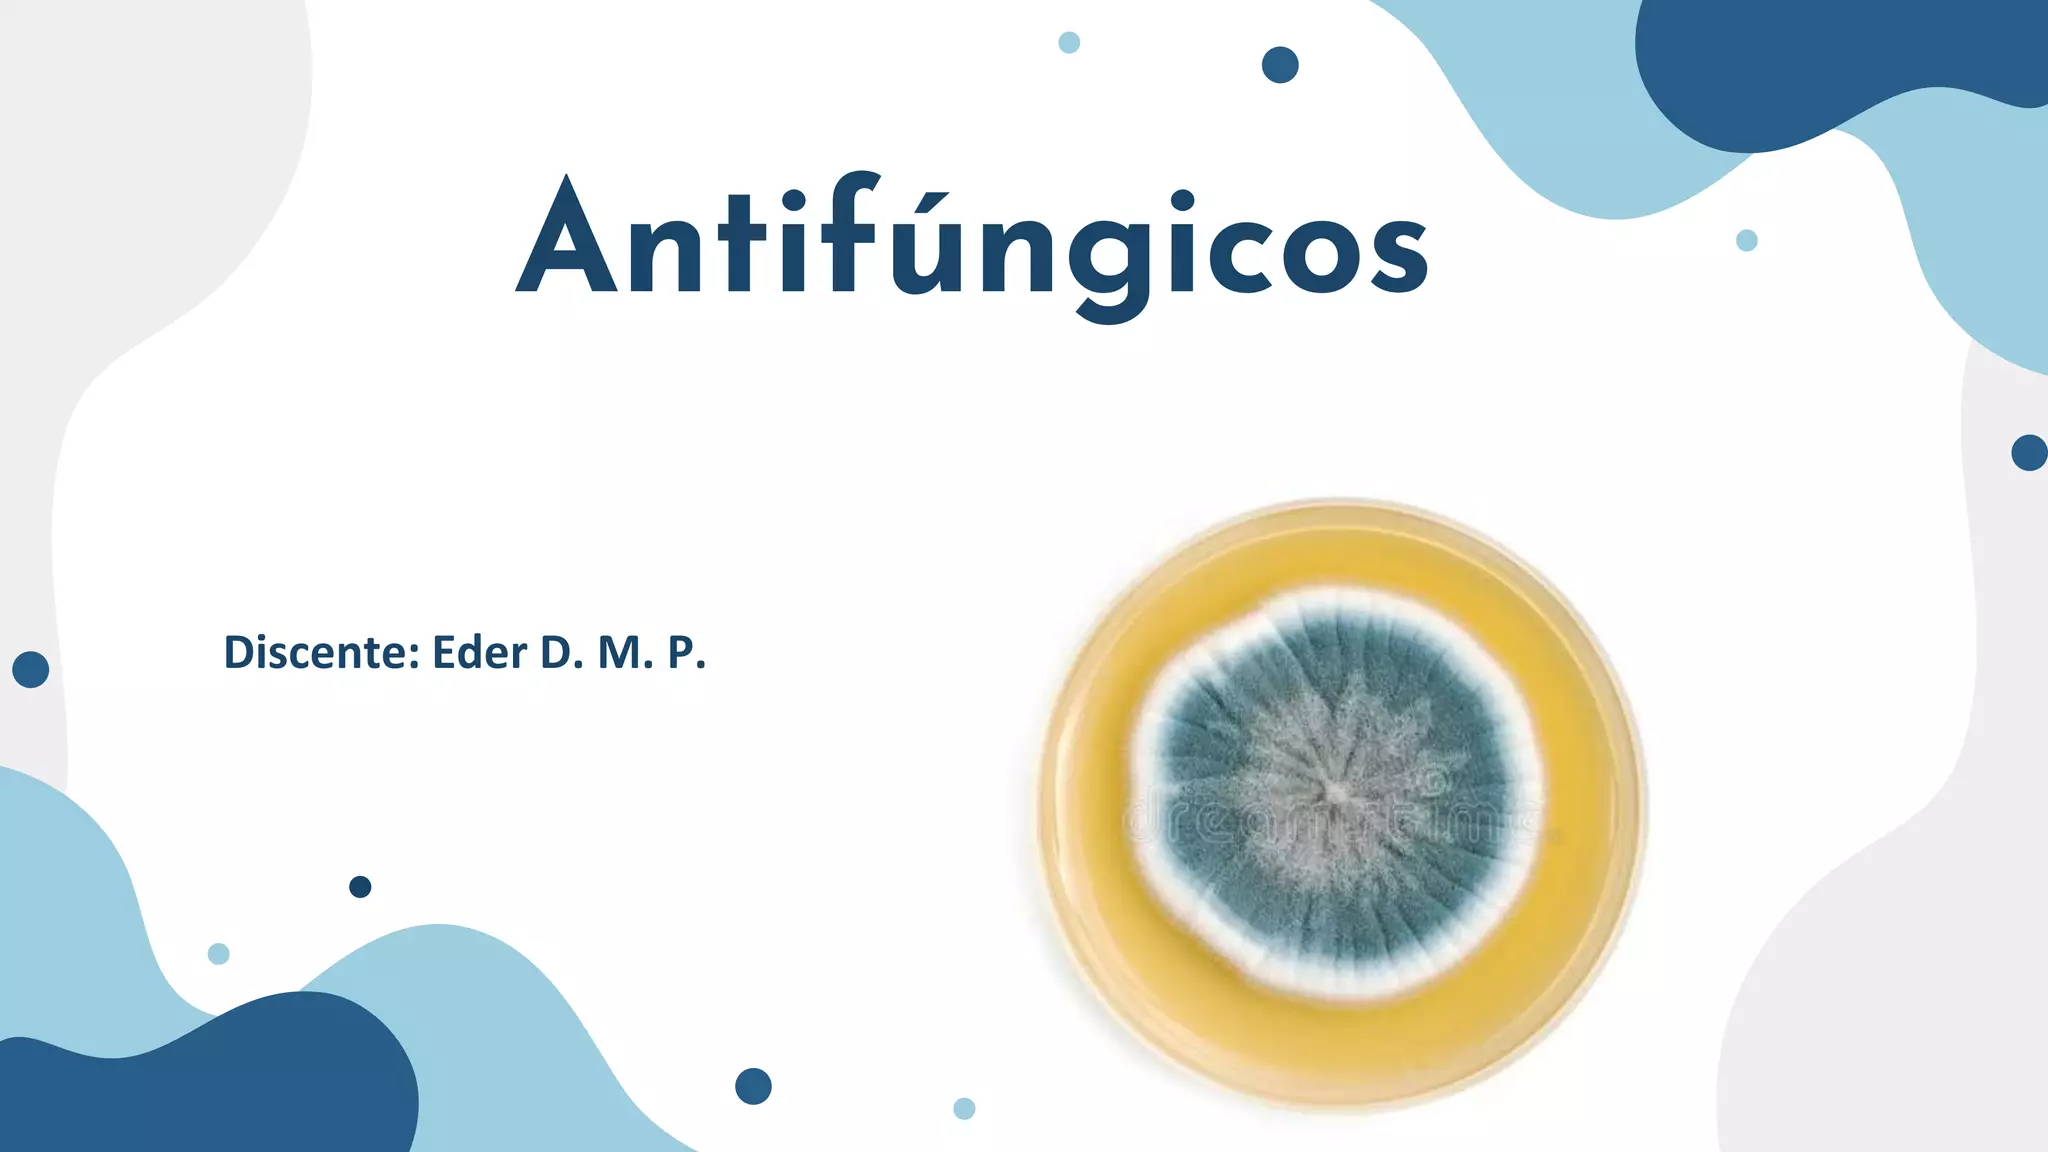

Este documento classifica os principais tipos de fungos, descreve os mecanismos de infecção fúngica e as classes de medicamentos antifúngicos. Apresenta os principais alvos farmacológicos dos antifúngicos, como a síntese de ácidos nucleicos, a mitose, a síntese do ergosterol e a estabilidade da membrana celular. Detalha diversos fármacos, incluindo suas vias de administração, mecanismos de ação, efeitos adversos e interações.